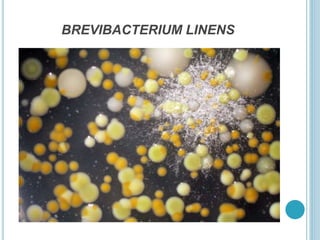
BREVIBACTERIUM LINENS
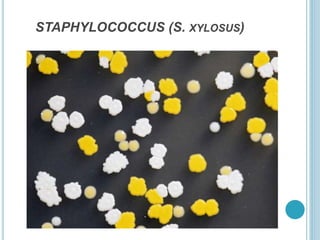
STAPHYLOCOCCUS (S. XYLOSUS)
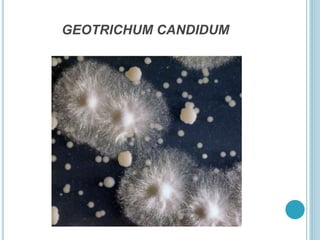
GEOTRICHUM CANDIDUM
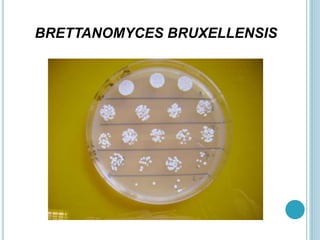
BRETTANOMYCES BRUXELLENSIS

The document discusses various aspects of microbes, highlighting their beneficial roles in health, agriculture, food production, and medicine. It details the various groups of microbes, their interactions, and their applications in probiotics, vaccines, and biofuels. Additionally, it examines how certain microbes can aid in the biodegradation of plastics, emphasizing their importance in environmental sustainability.